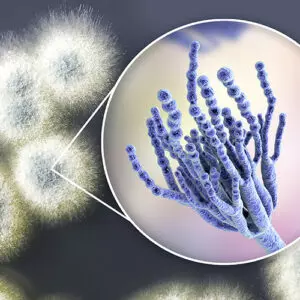

Was ist Schimmel
Was ist Schimmel?
Schimmel ist nicht gleich Schimmel. Er ist eigentlich überall in der Umgebungsluft vorhanden, kann aber verschiedene Farben und Ausprägungen haben. Gefährlich wird er vor allem, wenn er in einer komprimierten Anzahl auftaucht. Dann kann er neben der Beschädigung von Möbeln, Kleidern und ganzen Immobilien auch große Gesundheitsschäden hervorrufen. Wie Schimmel entsteht und welche Vorraussetzungen Schimmelbefall besonders begünstigt, erfahren Sie hier.
Schimmelpilze gibt es überall
Schimmel ist kein biologischer Fachbegriff, er wird für oberflächig auf Organismen und Stoffen wachsenden Pilzmyzelien und Sporenträge verwendet. Biologisch gesehen sind Pilze etwas besonders, weil sie eine eigenständige Lebensform darstellen. Sie gehören weder zu den Tieren noch zu den Pflanzen. In der freien Natur haben Schimmelpilze eine wichtige Rolle im Stoffkreislauf, da sie ihre Energie aus dem Abbau organischer Stoffe gewinnen. Es gibt etwa 100.000 schon bekannte- und vermutlich 250.000 Schimmelarten insgesamt. Aber nicht alle sind gleich. Nur ca. 200 Arten werden mit Erkrankungen von Mensch und Tier in Verbindung gebracht und weniger als 100 sind relevant für Innenräume.Zuerst einmal ist wichtig zu verstehen, dass Schimmelpilze überall in der Umgebungsluft vorhanden sind – sowohl draußen, als auch in Gebäuden z.B. an Decken und Wänden.
Wann ist Schimmel für Menschen gefährlich?
Als Schadorganismen, können Schimmelpilze giftige Stoffwechselprodukte freisetzen. Dies tritt vor allem durch Befall von Lebensmitteln und organischen Materialien im Wohnbereich auf. Aber erst eine erhöhte Konzentration und schimmelfördernde Voraussetzungen machen die Sporen zum Problem, welches Sie nicht unterschätzen sollten. Denn Schimmelpilze können nicht nur zu hohen finanziellen Schäden durch Befall von Wänden, Möbeln und des Mauerwerks führen. Auch gesundheitlich ist Schimmel sehr bedenklich und kann durch die Atemluft aufgenommen zu Allergien und schweren Atemwegserkrankungen führen. Daher sollten Sie den Schimmelpilz schnellstmöglich bekämpfen.
Wie wächst Schimmel?
Wie wächst Schimmel?
Schimmel wächst in zwei Phasen. In der ersten Phase verbreitet sich das Myzell, sobald die Sporen gute Bedingungen gefunden haben. Diese herrschen bei einer hohen Luftfeuchtigkeit und geeigneten Temperaturen, die bei verschiedenen Pilzarten unterschiedlich hoch sein können. Das Myzell selbst ist ein Geflecht aus Zellfäden, der sogenannten „Hyphen“. Diese wachsen hervorragend auf organischen Stoffen – also auf ziemlich jedem Untergrund im Haus. Deshalb sind Wände, Holzmöbel oder auch Kleidungsstücke der ideale Nährboden für Schimmel. In der ersten Phase können Sie Schimmel meist noch nicht erkennen. Erst in der zweiten Phase wird er sichtbar und bekommt seine charakteristische, oft schwarze Farbe. Aber auch grüne, gelbe oder weiße Schimmelpilze sind möglich. Jetzt bildet sich eine Schicht aus Fruchtkörpern, die auch die Sporen bilden. Eine Ausbreitung von Schimmelpilzen erfolgt über Luftbewegungen, bei denen Sporen und Partikel an einen anderen Ort getragen werden. Schimmelbefall tritt aber nicht nur in den Räumen auf, wo man generell eine hohe Luftfeuchtigkeit erwartet – also z.B. im Bad oder der Küche. Auch im Schlafzimmer findet Schimmel geeignete Bedingungen, z.B. durch die Feuchtigkeit, die ein Mensch beim Schlafen absondert und die meist niedrigere Zimmertemperatur als in anderen Räumen.
Schimmel Bildung: Hohe Luftfeuchtigkeit kann zu Schimmel führen
Da Schimmel sich also so ziemlich an allen Oberflächen in einem Gebäude festsetzen kann, können Sie das Schimmelrisiko hauptsächlich nur über die richtige Luftfeuchtigkeit in den Griff bekommen. Das bedeutet, Sie sollten darauf achten, die Luftfeuchtigkeit in Ihrem Zuhause nicht zu sehr ansteigen zu lassen – sie liegt für ein optimales Raumklima zwischen 40-60 %. Um die Luftfeuchtigkeit zu messen, verwenden Sie einfach ein Hygrometer. Dieses zeigt Ihnen den genauen Wert an. Außerdem sollten Sie darauf achten, Möbel nicht zu nah an Wände zu stellen. Denn hinter Schränken und Co. findet Schimmel perfekte Bedingungen. Der nötige Abstand beträgt bei allen Wänden mindestens 5 cm. Bei Außenwänden sollte er vergrößert werden: allgemein auf 10 cm und auf 15 cm bei vollflächig bedeckenden Schränken. So gewährleisten Sie einen geeigneten Luftaustausch und machen dem Schimmel das Leben schwer. Mit mehreren Stoßlüftungen für jeweils ca. 10 Minuten fördern Sie außerdem die Luftzirkulation zusätzlich in gefährdeten Räumen. Tipp: Dabei ist eine Stoßlüftung für ein paar Minuten aus energetischen Gesichtspunkten immer besser als ein gekipptes Fenster über eine längere Zeit.
Fazit
Es gibt viele bekannte und noch mehr unbekannte Schimmelarten. Sie können die Sporen aus dem eigenen Zuhause aber nicht „aussperren“, sondern nur dafür sorgen, dass Sie sich nicht in hoher Konzentration festsetzen. Dafür sollten Sie die Luftfeuchtigkeit im Auge behalten und mit ein paar einfachen Maßnahmen weitestgehend im optimalen Wohlfühlbereich von 40 -60 % halten.
MELLERUD bietet ein umfangreiches Sortiment zur Schimmelbekämpfung und Schimmelvorbeugung an. Mit MELLERUD gelingt es Ihnen leicht, Schimmel zu erkennen, Schimmel zu bekämpfen und sich dauerhaft vor Schimmelbefall zu schützen. Jetzt alle Produkte im Online Shop entdecken!



